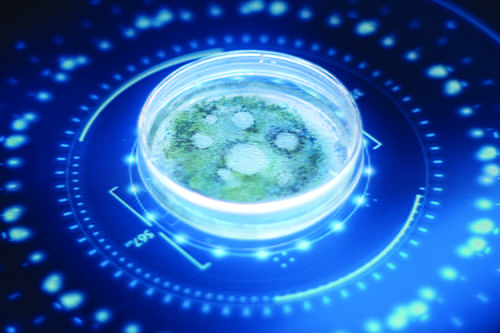
A close up of a petri dish with speciemen in it.

In many clinical laboratory disciplines, including clinical chemistry, molecular biology, immunology, and hematology, automation is now being used to complete every step of the workflow (1). Such “total” automation has been considered difficult to achieve in clinical microbiology due to the different microbiological specimen collection sites, from which microbiological specimens are collected, the complexity of their containers, the need to test for a large number of pathogens, and the high cost of automation relative to low specimen volumes (2,3).
However, that may be changing. Thanks to advances in technology and more centralized laboratory models, microbiology laboratory automation (MLA) systems have been developed and many labs worldwide are implementing MLA systems, which offer the potential to streamline workflows, optimize incubation conditions, improve the ability to track samples, and reduce errors and injuries.
Today, there are two major commercially available MLA systems: Kiestra by BD (Becton, Dickinson and Company) and WASPLab by Copan Diagnostics, Inc. This article explores the current state of MLA and highlights some exciting new developments that could shape the future.
An automated specimen processor can inoculate liquid-based specimens onto solid media or broth media. Once these specimens are scanned and loaded onto a processor, they are inoculated onto culture media that are pre-selected for their specific specimen type. A processor can store numerous types of culture media and label specimens with a barcode prior to inoculation for tracking and tracing. It also has a verification system to ensure that specimens are actually inoculated.
Non-liquid-based specimens can be processed semiautomatically. In other words, lab staff must manually inoculate them onto media and then add them to a processor for further steps. The inoculated solid media plates are streaked with a loop (Copan’s WASP-DT) or a magnetic bead (BD’s InoqulA). Lab staff have the option of selecting a streaking pattern from a library or customizing their own pattern.
In addition, these systems can prepare slides automatically for Gram staining. As one might expect, automating specimen processing can reduce variability from manual plate streaking, minimize cross contamination, alleviate the risk of repetitive strain injury or exposure to hazardous material, and reduce the costs and time associated with specimen processing (3).
Once specimen processing is complete, these automated systems transport plates on a conveyor belt to an incubator with the appropriate atmospheric conditions. MLA incubators have high storage capacities (795 to 1590 plates for WASP, 1,152 plates for Kiestra) and provide stable aerobic and CO2 atmospheres at constant temperatures. Users will receive a high-resolution digital image of a plate after it enters the incubator, and again at specific incubation times that they predefine based on specimen type. Additional images can be obtained at any time a user requests them.
The systems capture images of the plates at several light exposures and various angles. These images are then used to monitor the cultures. Using MLA software, lab staff can view the images at high magnification and assess images of different specimen types taken at various incubation times from the same patient. This can aid them in interpreting the culture.
Automated plate processes offer several advantages over standard workflows. They reduce the time that plates spend outside an incubator, thus optimizing incubation conditions and enhancing bacterial growth, including the emergence of rarely recovered and fastidious organisms (4,5), and they decrease the likelihood of contamination. They also allow for a more continuous workflow, which is better suited to a 24/7 operation, as opposed to batch processing (2).
Laboratory staff can use MLA software to read and interpret digital images of plates and mark on the screen which colonies require further work up, including subculture, organism identification, and antimicrobial susceptibility. They then can collect the plates with marked colonies from their incubator for further analysis.
There is an MLA product on the market that integrates artificial intelligence (AI) to automate the evaluation of plates. PhenoMatrix by Copan uses algorithms to detect organisms of interest, including methicillin-resistant Staphylococcus aureus (MRSA), vancomycin-resistant Enterococci (VRE), and group B streptococcus (GBS) on a chromogenic agar. Its performance has been evaluated and published (6–9).
PhenoMatrix also can segregate urine cultures according to whether they have no growth, growth, insignificant growth, or mixed growth. Moreover, users can specify colony counts for the software to do additional triaging. For example, the system can categorize urine cultures with less than 10 colony forming units (cfu). The software offers automatic colony recognition on standard media, and it can apply rules defined by users for more specified segregation algorithms.
BD Kiestra offers an imaging application for urine cultures and MRSA through its informatics system, which is called BD Synapsys (10,11). By using an AI algorithm coupled with user-created rules, the system can interpret digital images of plates with verified media, including certain chromogenic agars. It can segregate no growth or clinically nonsignificant growth based on user-defined rules.
A technology called matrix-assisted laser-desorption ionization – time-of-flight mass spectrometry (MALDI-TOF MS) has revolutionized the identification of bacteria and fungi. It identifies organisms by analyzing their protein profiles and comparing them against known values in a database (3). MALDI-TOF MS has largely replaced traditional biochemical methods for identifying organisms because of its rapid turnaround time, low requirements for specimen volume, and per-test affordability (2).
There are two main systems on the market for MALDI-TOF MS, both of which are semiautomated: Bruker’s MALDI Biotyper CA and bioMérieux’s VITEK MS. In both cases, lab staff must manually prepare samples, which includes picking colonies from culture plates, spotting on sample plates, and applying matrices. The exception to this is if the lab has an MLA system in place to automate sample preparation.
For example, BD’s IdentifA received approval from the Food and Drug Administration (FDA) to be used with Bruker’s MALDI Biotyper CA. In addition, Colibri is FDA-cleared for use with Bruker’s MALDI Biotyper CA and bioMérieux’s VITEK MS. Colibri can be coupled with an AI system called PhenoMATRIX TAG, which automatically tags colonies on a culture plate to be picked by Colibri based on growth interpretation, as defined by custom rules.
There are also automated instruments available to help lab staff conduct antimicrobial-susceptibility testing (AST), one of their major responsibilities in clinical microbiology laboratories. Some automated AST instruments use broth microdilution methods that require manual preparation of a McFarland suspension. Copan’s Colibri can prepare McFarland suspensions automatically with a nephelometer, and it is FDA cleared for use with bioMérieux’s VITEK 2. It also prepares a plate for conducting a purity check from the suspension.
For disk-diffusion methods, the Radian system by Copan fully automates disk-diffusion testing by seeding Mueller Hinton plates with an automatically prepared McFarland suspension. It applies antimicrobial disks onto the seeded plate, providing digital images of the plate for automated zone diameter measurement and interpretation (12).
Advances in machine learning and AI are expected to bring further developments to clinical microbiology laboratories. For example, in a 2018 study, researchers evaluated automated Gram stain interpretation of blood cultures, supporting a proof of concept for a fully automated classification methodology (13). With MLA’s automated Gram stain slide preparation and high-resolution digital imaging, one can envision a future where MLA offers a fully automated Gram stain process that includes Gram stain interpretation by AI.
In addition, as the use of AI for reading culture plates evolves, its applications may expand to cover more diverse specimen types (e.g., samples from stool, wounds, respiratory tract, etc.) for a wider range of organisms. Furthermore, if guidelines for disk-diffusion testing from positive blood culture broths can be applied to automated disk-diffusion AST processes, laboratorians may have a reliable and timely new option for retrieving one of the most critical test results in the clinical microbiology lab.
Although automating clinical microbiology laboratories brings challenges, technological advancements are rapidly expanding the realm of possibility. Since the first automated system for clinical microbiology was installed in 2006, multiple laboratories worldwide have implemented MLA.
Such systems can provide multiple advantages to clinical microbiology laboratories. First, they improve workflow by automating processes that are often time consuming and tedious when done manually, such as plate sorting, plate moving, plate streaking, and locating plates. By allowing more continuous workflows, the working hours of the laboratories can be extended, which benefits patient care.
In addition, standardized streaking yields a higher amount of isolated colonies and uninterrupted incubation processes, thereby improving the recovery of pathogens from culture (3–5). MLA also reduces human error (during plate streaking, labeling, etc.), which increases the quality of microbiological test results. Furthermore, eliminating the need for lab staff to perform repetitive tasks can alleviate ergonomic issues (3).
MLA’s ability to provide reproducible results with image documentation is another strength. When combined with its barcoding capability, digital imaging offers traceability that can be helpful to laboratories (3,14). Digital images and traceability also create great learning opportunities for students and trainees, allowing them to view saved images at different timepoints. Moreover, some research indicates that MLA has a faster turnaround time than traditional setups (15,16), which could positively impact patient care and treatment cost.
Finally, the economic benefit that comes with improving laboratory efficiency cannot be overlooked, especially since microbiology laboratories are facing increasing testing demands while experiencing staffing shortages (16). Of course, this must be weighed against the high initial costs for procuring and installing MLA.
Certainly, system installation brings with it the risk of downtime and the need for a backup plan. However, it’s helpful to bear in mind that MLA systems are modular in nature and that levels of automation can be individualized (3), allowing for a gradual transition.
Understanding the current state of automation in clinical microbiology, along with possible new developments on the horizon, is a good way to ensure your laboratory is on the best path.
Do Young Kim, MD, at the time of writing this article, was a medical microbiology fellow in the department of pathology and laboratory medicine, NorthShore University Health System, and the department of pathology at the Pritzker School of Medicine at the University of Chicago. +Email: [email protected]
1. Burckhardt I. Laboratory automation in clinical microbiology. Bioengineering 2018; 102.
2. Cherkaoui A, Schrenzel J. Total Laboratory Automation for rapid detection and identification of microorganisms and their antimicrobial resistance profiles. Front Cell Infect Microbiol 2022; 67.
3. Doern CD, Holfelder M. Automation and Design of the Clinical Microbiology Laboratory. Man Clin Microbiol 2015; 44–53.
4. Klein S, Nurjadi D, Horner S, et al. Significant increase in cultivation of Gardnerella vaginalis, Alloscardovia omnicolens, Actinotignum schaalii, and Actinomyces spp. in urine samples with total laboratory automation. Eur J Clin Microbiol Infect Dis 2018; 37:1305–11.
5. Lainhart W, Burnham CAD. Enhanced recovery of fastidious organisms from urine culture in the setting of total laboratory automation. J Clin Microbiol 2018.
6. Faron ML, Buchan BW, Coon C, et al. Automatic digital analysis of chromogenic media for vancomycin-resistant-enterococcus screens using Copan WASPLab. J Clin Microbiol 2016; 54:2464–9.
7. Faron ML, Buchan BW, Vismara C, et al. Automated Scoring of Chromogenic Media for Detection of Methicillin-Resistant Staphylococcus aureus by Use of WASPLab Image Analysis Software. J Clin Microbiol. American Society for Microbiology (ASM); 2016; 54:620–4.
8. Baker J, Timm K, Faron M, et al. Digital image analysis for the detection of group B Streptococcus from ChromID strepto B medium using phenomatrix algorithms. J Clin Microbiol 2021; 59.
9. Kirn TJ. Automatic digital plate reading for surveillance cultures. J Clin Microbiol 2016;2424–6.
10. Gammel N, Ross TL, Lewis S, et al. Comparison of an automated plate assessment system (APAS Independence) and artificial intelligence (AI) to manual plate reading of methicillin-resistant and methicillin-susceptible Staphylococcus aureus CHROMagar Surveillance Cultures. J Clin Microbiol. J Clin Microbiol 2021; 59.
11. Patel P, Droske LE, Patel J, et al. 2152. Detection of uropathogens using BD KiestraTM total laboratory automation with urine culture application. Open Forum Infect Dis. Oxford Academic; 2019; 6:S730–S730.
12. Cherkaoui A, Renzi G, Vuilleumier N, et al. Performance of fully automated antimicrobial disk diffusion susceptibility testing using copan wasp colibri coupled to the radian in-line carousel and expert system. J Clin Microbiol 2021; 59.
13. Smith KP, Kang AD, Kirby JE. Automated interpretation of blood culture gram stains by use of a deep convolutional neural network. J Clin Microbiol 2018; 56.
14. Leo S, Cherkaoui A, Renzi G, et al. Mini Review: Clinical routine microbiology in the era of automation and digital health. Front Cell Infect Microbiol 2020; 706.
15. Yarbrough ML, Lainhart W, McMullen AR, et al. Impact of total laboratory automation on workflow and specimen processing time for culture of urine specimens. Eur J Clin Microbiol Infect Dis. Springer 2018; 37:2405–11.
16. Culbreath K, Piwonka H, Korver J, et al. Benefits derived from full laboratory automation in microbiology: A tale of four laboratories. J Clin Microbiol. 2021; 59:1969–89.